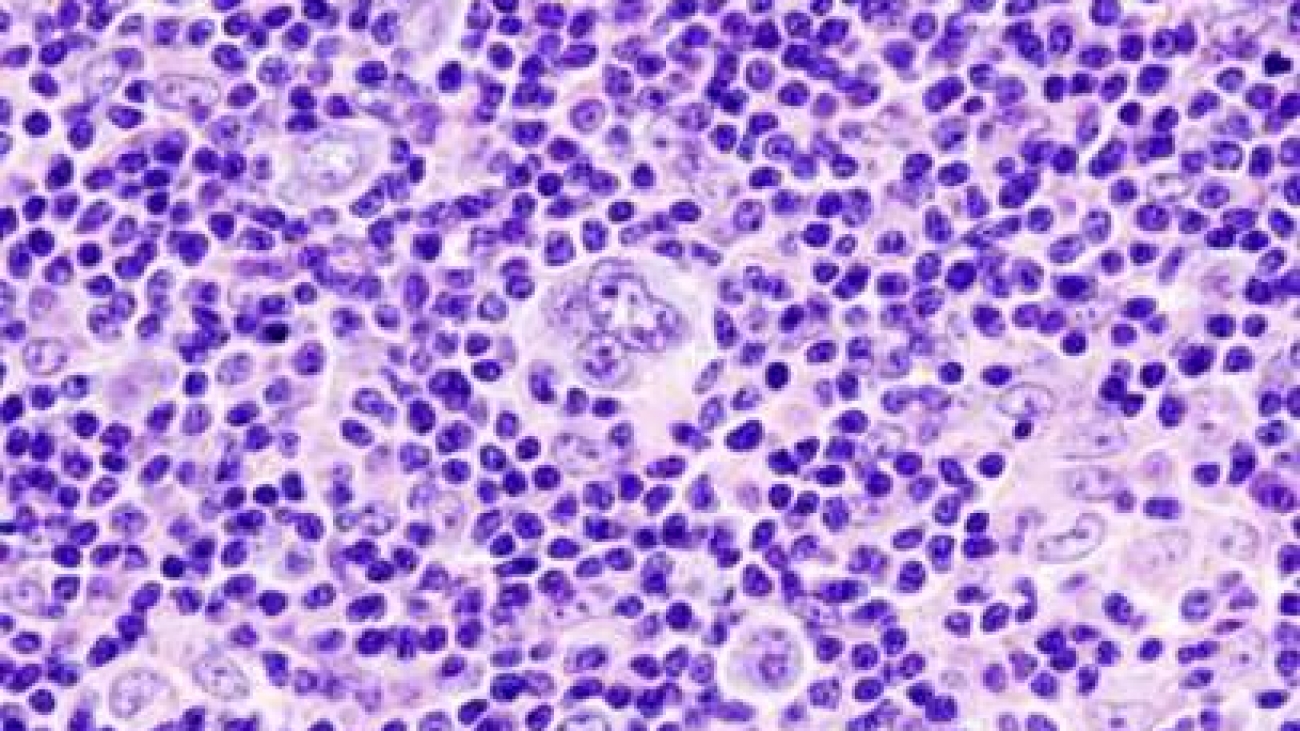

Haematology involves the diagnosis and treatment of patients who have disorders of the blood and bone marrow. Whilst a major part of a haematologist’s time is spent in providing direct clinical care to patients, diagnostic work in the laboratory is also a significant part of their work.
WHY IS HAEMATOLOGY IMPORTANT?
Haematology is the specialty responsible for the diagnosis and management of a wide range of benign and malignant disorders of the red and white blood cells, platelets and the coagulation system in adults and children.
Haematologists care directly for patients on hospital wards and out patient clinics. Their patients may have a serious life- threatening illness such as leukaemia, lymphoma or myeloma that requires chemotherapy. They also advise GPs about how to care for patients in their homes. Some haematologists specialise in diseases affecting the blood coagulation system such as haemophilia, while others provide expertise in the areas of blood transfusion or disorders of haemoglobin such as sickle cell disease.
THE ROLE OF THE HAEMATOLOGIST
Haematologists work very closely with other health professionals including GPs, pharmacists and specialist nurses, advising colleagues in hospital and primary care.
Haematologists perform a wide range of laboratory tests to produce and interpret results assisting clinicians in their diagnosis and treatment of disease whilst supporting hospital departments including A&E, intensive care, operating theatres, special care baby units and oncology.
For example, haematologists are the pathologists who receive blood samples from GP surgeries and check them for abnormalities. They look at blood film and, for example, if they suspect leukaemia, can assess the patient, explain concerns, perform a bone marrow biopsy and examine and interpret the samples. The diagnosis can be done within a few hours, since in some cases treatment must be started immediately.
Haematologists also diagnose and treat patients with anaemia (a lower than normal number of red blood cells).
Some haematologists are involved in transfusion medicine, ensuring that adequate stocks of safe blood are available when needed for blood transfusions. They confirm which donated blood is the right match for the patient’s blood group. For example, haematologists work in the NHS Blood and Transplant service providing vital support for blood transfusion, organ and stem cell transplantation.
They also undertake research into diseases such as leukaemia. By gaining understanding of diseases they also research therapies to help improve survival rates of patients.